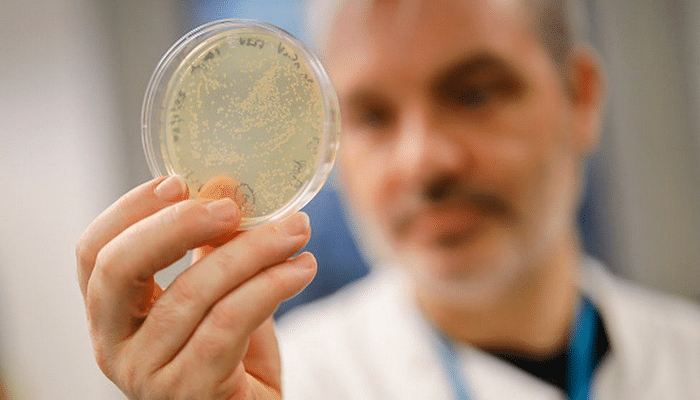
Koronavirus Azərbaycan iqtisadiyyatına nə qədər ziyan vurur? – Açıqlama

Müəllif: izzet qurbanov
Müəllif: Administrator